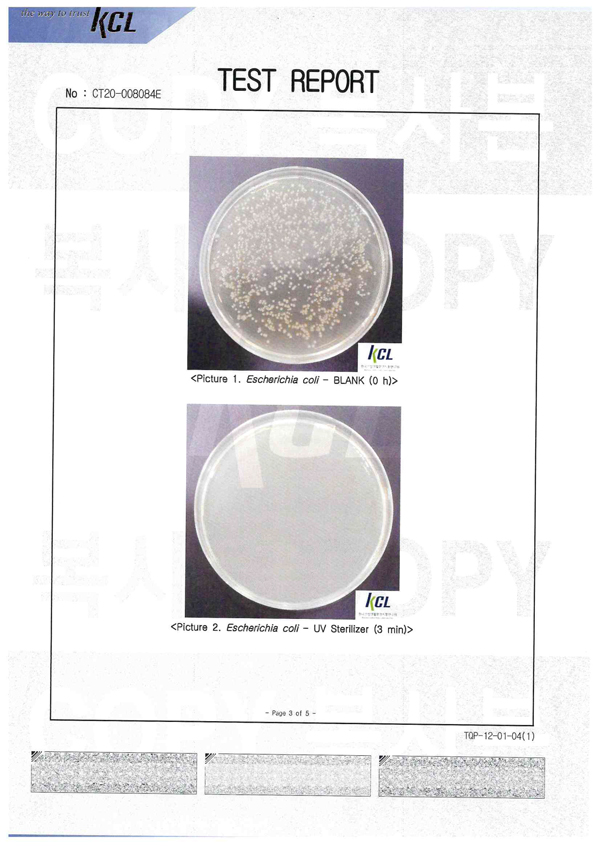

Đèn UV cầm tay EssGee diệt khuẩn và virus trong 10 giây
- Nhà sản xuất: ILLUCO-KOREA
- Mã sản phẩm: ESSGEE-003
- Tình trạng: Còn hàng
- Giá thị trường: 2.400.000 VND29%Giá Khuyến mãi: 1.699.000 VND
Như các bạn đã biết việc dùng các dung dịch diệt khuẩn đôi khi khiến thiết bị của người dùng bị bong tróc lớp mạ bên ngoài hoặc thậm chí ảnh hưởng tới chất lượng.
Vì thế, việc dùng các tia UV để diệt khuẩn được đánh giá cao hơn, bởi tia UV có thể giết hoặc làm bất hoạt các vi sinh vật, bằng cách phá huỷ các Acid Nucleic và phá hoại DNA của chúng, khiến chúng không thể thực hiện chức năng tế bào quan trọng, ngăn chặn sự lây lan. ·

ỨNG DỤNG
Loại bỏ virus và vi khuẩn mà mắt thường không nhìn thấy được một các dễ dàng ở bất cứ chỗ nào mà bạn cảm thấy không yên tâm và cần diệt khuẩn, khử trùng như: Khẩu trang, điện thoại, bàn phím, nút bấm thang máy, điều khiển, đồng hồ, tai nghe, nhẫn, giầy, ví, son, cốc, tay nắm cửa, những đồ dùng trong nhà như: chăn, ga, gối ….đặc biệt là những đồ mà trẻ em thường xuyên tiếp xúc như đồ chơi, bình sữa, núm ti, núm ti giả ….hay kể cả là cốc nguyệt san của chị e phụ nữ…

ƯU ĐIỂM SẢN PHẨM
- Kích thước nhỏ gọn ( 5.5x9.5x2cm ( khi đóng nắp trượt), dễ dàng mang theo bên mình
- Pin: pin Li-po, 500mAh, 1.85Wh, có dây cáp sạc điện micro USB dễ dàng sạc pin (nhẹ hơn so với pin Li-ion và có thể sạc đi sạc lại nhiều lần liên tục).
- Thiết kế với bộ phát con quay hồi chuyển lật ngược lại thiết bị tự động tắt nguồn, vì thế bạn có thể yên tâm sử dụng mà không sợ gây hại cho mắt.
- Thiết kế dạng trượt nên chỉ cần trượt và chiếu đèn về phía đồ vật cần xử lý là có thể dễ dàng diệt khuẩn.
- Khử trùng mạnh mẽ hoàn thành trong 10 giây
- Với 13 đèn UV LED kết hợp 2 tia tử ngoại:
+ UV-A có hiệu quả diệt khuẩn cao và mạnh.
+ UV-C có bức xạ lớn phù hợp khi diệt khuẩn nhanh. Sử dụng tốt kể cả khi muốn diệt khuẩn nhanh hay kể cả khi muốn diệt khuẩn lâu, liên tục.

CHỨNG NHẬN AN TOÀN
- Chứng nhận tiêu chuẩn CE
- Được kiểm chứng bởi KATR và KRICT
THÔNG SỐ KỸ THUẬT
- Input:5V、0.43A
- Pin:Pin Li-po、500mAh、1.85Wh (nhẹ hơn so với pin Li-ion và có thể sạc đi sạc lại nhiều lần liên tục).
- Thời gian sạc:Khoảng 1 tiếng 20 phút
- Thời gian sử dụng:Tối đa 70 phút.
- Đèn UV: UV-C LED (275nm・2 cái)、UV-A LED (390nm・11cái)、
- Đèn để xác định phạm vi chiếu sáng ( Đèn màu xanh, 4 cái)
- Khoảng cách chiếu sáng:Trong phạm vi bán kính là 20cm với khoảng cách tiêu chuẩn là 5cm (Càng để gần thì tỷ lệ diệt khuẩn càng cao)


QUY CÁCH ĐÓNG GÓI - MÀU SẮC
- Bộ sản phẩm bao gồm: 01 máy diệt khuẩn, 01 dây cáp sạc và 01 hướng dẫn sử dụng
- Trọng Lượng: 70g.
- Kích thước: 5.5x9.5x2cm ( khi đóng nắp trượt).
- Màu sắc: 4 màu ( Đỏ đun, xanh ngọc, đen, trắng )

HƯỚNG DẪN SẠC PIN
1. Khi pin cần sạc, đèn đỏ sẽ được bật ở đèn chỉ báo LED trong khi sản phẩm đang được sử dụng
2. Khi nắp trượt mở nhưng hết pin, đèn UV sẽ không sáng và đèn đỏ sẽ nhấp nháy trên đèn LED.
3. Quá trình sạc bắt đầu khi đóng nắp trượt và khi sản phẩm được kết nối với ổ cắm thích hợp của cáp sạc USB. (Bạn có thể sử dụng bộ chuyển đổi với cáp USB 5 chân siêu nhỏ mà bạn có cho bộ sạc điện thoại thông minh hoặc pin phụ)
4. Việc hoàn thành sạc sẽ được chỉ định khi đèn xanh dừng nhấp nháy và tiếp tục bật.
5. Mất khoảng 1 giờ 20 phút để sạc đầy sản phẩm và có thể sử dụng liên tục trong tối đa 1 giờ 10 phút.
HƯỚNG DẪN SỬ DỤNG ĐÈN UV ESSGEE
1. Không trực tiếp nhìn vào ánh sáng từ đèn UV. (Bạn có thể đeo kính vì ánh sáng tia cực tím không thể xuyên qua kính hoặc nhựa trong suốt; Tuy nhiên, cách tiếp cận như vậy vẫn cần được xử lý một cách thận trọng và không được khuyến khích.)
2. Giữ sản phẩm xa tầm tay trẻ em và đảm bảo rằng trẻ em không sử dụng hoặc chơi với nó.
3. Xin đừng chiếu đèn UV về phía người, động vật.
4. Hãy cẩn thận với nước vì sản phẩm không chống nước
5. Vui lòng không tự mình tháo rời hoặc sửa đổi sản phẩm và liên hệ với trung tâm dịch vụ nếu cần.
KẾT QUẢ BÁO CÁO VI KHUẨN VÀ VIRUS CORONA

Tag: Đèn led, UV, EssGee, diệt khuẩn, virus, corona, đèn cầm tay





















